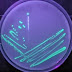

Mengenal Bakteri Bacillus polymyxa
Agrotekno Lab
Jual culture Bacillus polymyxa
Bacillus polymyxa merupakan
bakteri yang menghasilkan antibiotik polimiksin B yang dapat dimanfaatkan untuk
pengobatan infeksi bakteri gram negatif, sedangkan Bacillus subtilis adalah
bakteri penghasil antibiotik untuk pengobatan infeksi bakteri gram positif.
Streptomyces griseus penghasil antibiotik streptomisin untuk pengobatan bakteri
gram negatif termasuk bakteri penyebab TBC dan Streptomyces rimosus penghasil
antibiotik terasiklin untuk berbagai infeksi bakteri.
Bakteri Bacillus polymyxa
termasuk jenis bakteri yang menguntungkan di bidang kesehatan, bidang
lingkungan dan pangan karena mengandung antibiotik dimana antibiotik merupakan zat yang dihasilkan oleh
mikroorganisme dan mempunyai daya hambat terhadap kegiatan mikroorganisme lain.
Antibiotik yang efektif bagi banyak spesies bakteri, baik kokus, basil, maupun
spiril, dikatakan mempunyai spektrum luas. Sebaliknya, suatu antibiotik yang
hanya efektif untuk spesies tertentu, disebut antibiotik yang spektrumnya
sempit. Pinisilin hanya efektif untuk membrantas terutama jenis kokus, oleh
karena itu pinisilin dikatakan mempunyai spektrum yang sempit. Tetrasiklin
efektif bagi kokus, basil dan jenis spiril tertentu, oleh karena itu
tetrasiklin dikatakan mempunyai spektrum luas. Sebelum suatu antibiotik digunakan
untuk keperluan pengobatan, maka perlulah terlebih dahulu antibiotik itu diuji
efeknya terhadap spesies bakteri tertentu.
Nama ilmiah :
Paenibacillus polymyxa
Nama lain :
› "Aerobacillus
polymyxa" (Prazmowski 1880) Donker 1926
› "Clostridium
polymyxa" Prazmowski 1880
›
"Granulobacter polymyxa" (Prazmowski 1880) Beijerinck 1893
› Aerobacillus
polymyxa
› Bacillus polymyxa
(Prazmowski 1880) Mace 1889 (Approved Lists 1980)
› Clostridium
polymyxa
› Granulobacter
polymyxa
› Paenibacillus
polymyxa (Prazmowski 1880) Ash et al. 1994

test
BalasHapus